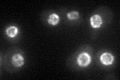
YML031W
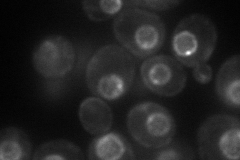
YML031W
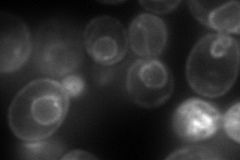
YML031W

View description
Nuclear envelope protein with multiple putative transmembrane domains, required for nuclear pore complex assembly and spindle pole body duplication; required for meiosis II
Localization:
Intensity:
Fold change:
Significance:
-
C’ GFP library in SD
nuclear periphery54.02 -
N' NOP1pr-GFP in SD
cell periphery,punctate,nuclear periphery87.4592 -
N' TEF2pr-mCherry in SD
cell periphery,ER,punctate155.276 -
N' NATIVEpr-GFP in SD

missing0 -
N' TEF2pr-VC and Cyto-VN in SD

#N/A0 -
C’ GFP library in SD+DTT

nuclear periphery42.10.77No -
C’ GFP library in SD+H2O2

nuclear periphery57.441.06No -
C’ GFP library in Starvation Media

nuclear periphery53.010.98No -
C’ GFP library on the background of Pup2-DaMP

N/A -
C’ GFP library on the background of CCT mutant

N/A0N/AYes
